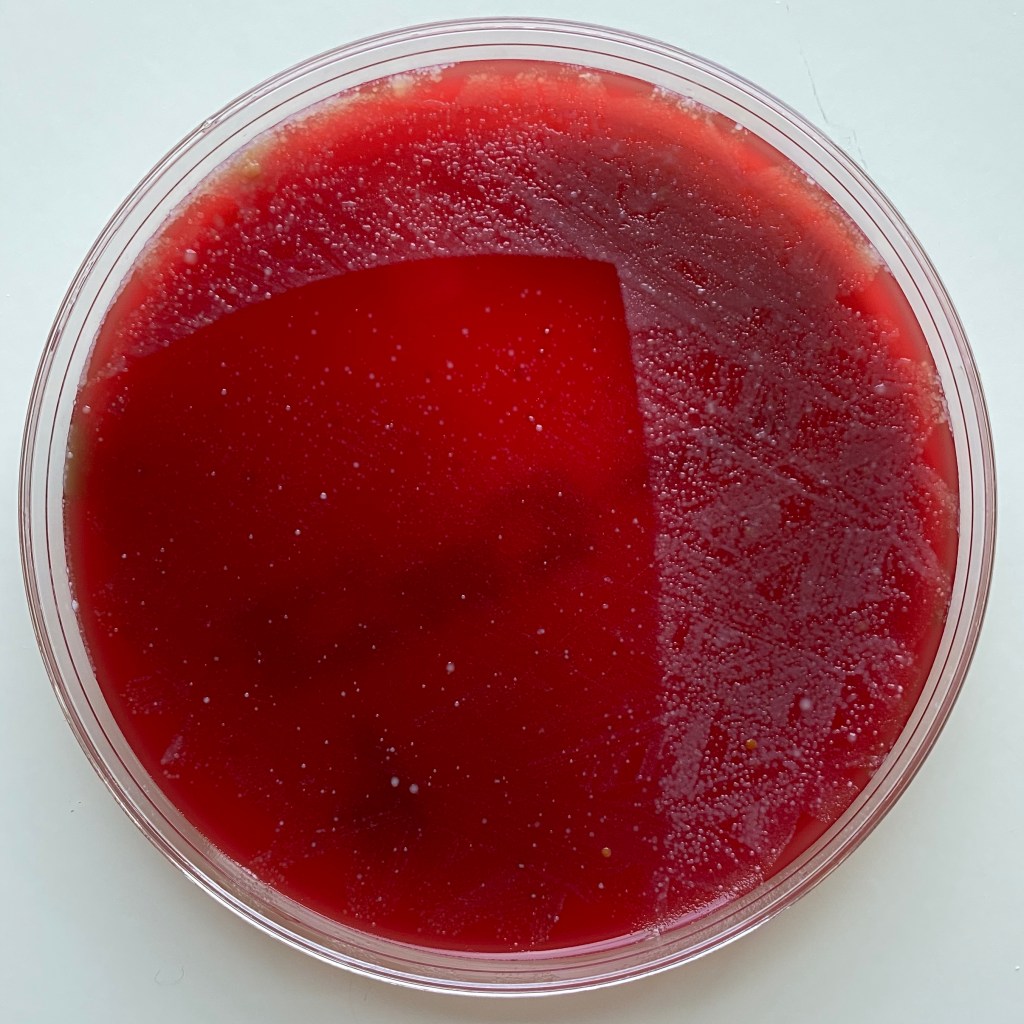

Recently I purchased a box on Amazon made by 59S to sterilize things using ultraviolet (UV) light. With the COVID-19 pandemic I have to think about masks that need to be reused, and my cellphone, keys, wallet, etc for the times I venture out. Sure I can wipe them down with disinfectant wipes, but those are in short supply, and can’t be used on everything.
This box puts out UV light in the 260-280 nm wavelength using LED lights, 15.6 watts, with a cycle of 3 minutes. The light is rated at 10,000 hours. That would be 200,000 treatments, though I’m not sure the zipper would last that long.
Given the almost $200 price, I was not only concerned about the possibility of having been ripped off, but was even more concerned that it might not work as advertised, and that things I thought had been sterilized might not actually be safe. Just because ultraviolet light is proven to be effective does not guarantee than any particular device works as advertised.
So I decided to purchase some Columbia Blood Agar, 5 Percent Sheep Blood plates to do a scientific experiment to test it. I used a method similar to this video, though I used a sleeve to cover the front, back, and sides of half of the petri dishes. Rather than a pure source of E coli, I just dipped a cotton swab in different sources (toilet bowl, dog water bowl, mouth). After a couple of days it clearly showed that the UV light worked with the bacteria only growing on the half that was shielded from the light, as shown below.

This box has 12 LED lights on the top and 12 on the bottom. So I knew it worked when exposed from above. The petri dish sits on little wire stand so it’s much closer to the bottom, so I had no concerns about adequate light on the bottom side, but what about the front, back, or sides of an object that might not be directly exposed to the lights? So I repeated the experiment, but propped up one dish perpendicular to the bottom and facing the front, and another facing the side.
Thanks to the reflective surface inside the box, it still worked, but not quite as well. As shown below, on a dish facing the front, the clear portion does not extend to the top (The scattered colonies in the clear part were not visible earlier. I’m uncertain if it represents a low level that was not killed, or maybe new grown from contamination from the air while examining the plate. I didn’t start with a pure bacteria nor have the means to distinguish the bacteria.) I had similar results on the side, and repeating this portion of the experiment.
I think the problem is that some items may fall into a shadow where they don’t get direct UV exposure, and they either don’t get indirect exposure from reflection, or if they do, they don’t get enough. Although just running a repeat cycle may fix the problem, a better solution would be to move the item to change the surfaces exposed to the front and bottom, and then repeat the cycle.
In practice, even if not perfect, it certainly decreases the risk of getting infected from the surface of an item treated. Most of the time the infection doesn’t take hold unless the number of bacteria or viruses exceeds the ability of the body to fight it off. Being mindful of where the lights are and how you’re putting things in the box may help.
I recommend the manufactures add lights to the front, back, and sides and perhaps change to a cylinder like a hat box.
Most cases of COVID-19 are probably transmitted from person to person via droplets, rather than from surfaces, but for those who can afford it, this device may lessen the risk of contracting it, or other infections, and provide peace of mind.
Heya! I’m glad to see a fellow physician doing experiments on this! I bought a 59s product, the T5 model, where it has 40 LED lights: 12 on top, 8 on 4 sides. The bottom has no LEDs but there are highly polished mirrors on the lid and bottom. I was worried if I was scammed as well, but glad to see 59s works! Check out the T5 model 🙂 it’s running out of stock in my country too.
Thanks. I hadn’t seen the T5 model before, but on the company’s site they advertise it as being for baby bottles.
It’s being advertised for baby bottles, and also as a CPAP sterilizing machine (funny how marketing works?). In China there’s ads that they have given both the P55 model you have and the T5 model I have to doctors and hospitals. Heck, even on the box of the T5 it says it is suitable for use in clinics and hospitals 😳 But I guess since the same UVC LED tech is used in both models, it should be fine? But I mainly use this machine to clean my shoes from the hospital and my other knick knacks (after I wiped it down with Virosol, to be sure)